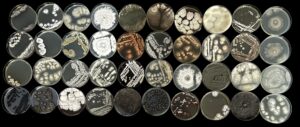
rows of petri dishes showing a variety of biodiversity cultures that exist in a alder tree

Winners 2025
Bee the Change (Fiona Hutton)

TillageCare is helping to show how practices such as cover cropping and the use of organic manures can improve soil health, store more carbon, and reduce nutrient losses to water.
By combining research, farmer experience, and data from real fields, the project supports industry and policymakers in developing a roadmap towards climate-neutral Irish crop production.
This photograph, taken at the Oak Park Open Day 2025, shows a flowering phacelia cover crop alive with pollinators such as this bumblebee—an example of how good soil management and biodiversity can thrive together.
Mosaic of flavor (Digvijay Digvijay and Prabin Lamichhane)

This project aims to extend the functional shelf-life of Irish cheeses to meet the demands of long-distance export markets in Asia.
To achieve this, we test approaches integrating food chemistry, engineering, and preservation techniques.
This micrograph of Irish Cheddar, crafted from grass-fed cow’s milk, reveals a colourful mosaic of protein interwoven with spherical fat pools.
This microstructure is the foundation of Cheddar’s unique sensory appeal: the protein-scaffold provides firmness, while the fat delivers creaminess and flavor.
Sheep at sunset – Achill Bay (Raquel Caetano Ferreira)

Photographed in Achill Bay, this scene of sheep grazing at sunset reflects the strong link between landscapes, farming, and food production in rural Ireland.
Sheep production in coastal areas faces challenges of climate, soil quality, and generational renewal. Yet these systems contribute to biodiversity, carbon storage, and vibrant local communities.
Through initiatives such as the FAIRshare project, Irish and European farmers are embracing digital and knowledge-sharing tools to strengthen these systems and ensure sustainable, connected, and innovative rural communities.
No Climbing on the Timber Stacks (Derek Gibson)
This photo was taken at the marteloscope training area in Oakpark.
The marteloscope consists of two forest plots, where all trees have been measured, numbered and catalogued in software accessible in the field via tablet.
The data is used to simulate forest thinning in real time, and to assess the financial and biodiversity impacts of any thinning decisions made.
This image of our native red squirrel was captured beside a stack of logs following a thinning, carried out to improve forest growth and health.
Culturable Fungal Diversity Associated with Common Alder (Emma Fuller)
This project explores the microbial communities associated with alder tree compartments to identify beneficial microbes that may support tree health and disease resilience.
The goal is to find nature-based, microbial solutions to help control Phytophthora alni, the pathogen responsible for alder dieback.
Fungal isolates cultivated from alder roots and leaves show a variety of morphological traits.
Each plate has unique textures, colours, and growth patterns, providing a glimpse into the biodiversity that exists within alder tree compartments.
These isolates are part of an ongoing effort to explore potential beneficial microbes that may contribute to alder health and disease resilience.
From grass to glass (Andre Brodkorb)

Irish milk from pasture-fed cows contains healthier fats than milk from cows kept indoors.
A study by Teagasc and Food for Health Ireland found that cows fed mostly fresh grass produce milk with 83% more omega-3, 141% more conjugated linoleic acids (CLA), more good unsaturated fats, and less saturated fat.
Grass feeding, common in Ireland but less so in other countries, is also seen as more natural and better for the environment, allowing cows to graze freely.
These results reinforce the reputation of Irish milk from grass-fed cows as nutritious, sustainable and better for consumers.
A tree with a future (Frances McHugh)

The image was captured in the woods in Oak Park, Carlow where ash trees thrive.
Although many ash trees in Oak Park are severely affected by ash dieback; there are some that show a high level of tolerance.
This tree reminds us of the potential of ash and that we can remain optimistic that nature and science will restore this beautiful tree to the Irish landscape.
You can get involved in the AshForFuture project by identifying healthy, dieback-tolerant ash trees and reporting to AshforFuture@teagasc.ie
Bees weaving life’s threads on a globe thistle. (Mariana Macas and Barbara Biduski)

On a globe thistle bloom, bees gather in quiet harmony, sipping nectar while dusted with pollen. Each visit links flower to flower, weaving the unseen threads of life that sustain fields, forests, and food. In their delicate dance, they carry the weight of ecosystems with effortless grace.
Like these bees the researchers at the PCF Centre, Ashtown, are exploring the interconnected threads of innovation that sustain our modern food systems.
Their work focuses on the development of sustainable, nutritious, and enjoyable bakery products, using alternative proteins and fibrous flours such as pulses, legumes, buckwheat, and quinoa.
A kaleidoscope of colour – eating with our eyes. (Katie Hetherington)

“A vibrant display of potato varieties developed through the Teagasc Potato Breeding Programme, showcasing the remarkable genetic diversity within the crop. The rich colours — from deep purple and pink to creamy yellow— reflect ongoing efforts to breed potatoes that are visually appealing and environmentally resilient.
By combining consumer appeal with sustainability and food security, the programme demonstrates how science and innovation can shape the future of potato production.”
Clover, Methane and Sheep (Eoin Dunne)

Sheep graze on a clover-rich pasture beside a GreenFeed unit — a special device that measures the methane animals release as they breathe.
This work is part of the RumenVentory project, which studies how genetics, diet, and farming practices affect methane emissions from cattle and sheep.
By comparing results from different measurement methods, researchers can build a more accurate picture of how much methane livestock produce under real farming conditions. The findings will help refine Ireland’s greenhouse gas estimates and support the development of more sustainable livestock systems for the future.
Hidden Allies: Macrofungi and forest health (Dheeraj Rathore)

The JoNeF project focuses on the conservation of wild macrofungi in their natural habitats, promoting legal and scientific frameworks for protecting fungi in European forests.
By strengthening monitoring, awareness, and regulation, JoNeF supports biodiversity protection and sustainable forest management across Europe.
This photograph, taken in Kastaneri Forest, Greece, shows a wild mushroom (Russula sp.) emerging among autumn leaves. Such fungi are vital to nutrient cycling, tree health, and biodiversity.
Their conservation is essential for resilient forest ecosystems and is at the heart of JoNeF’s mission.
Icing on the cage (Maximilian Schughart)

Icy dewdrops form a beautiful pattern on both the top and underside of the mesh of an insect-proof cage in a winter barley field.
This photo was taken at sunset after a frosty day of fieldwork in December. As part of the ELEVATE project, 128 cages like this were set up in a large-scale field trial to investigate the impact of different aphid and crop virus species on yield losses.
By deepening our understanding of how virus strains, insect vectors, and weather interact, ELEVATE aims to improve forecasting tools and support more resilient, sustainable barley production in Ireland.